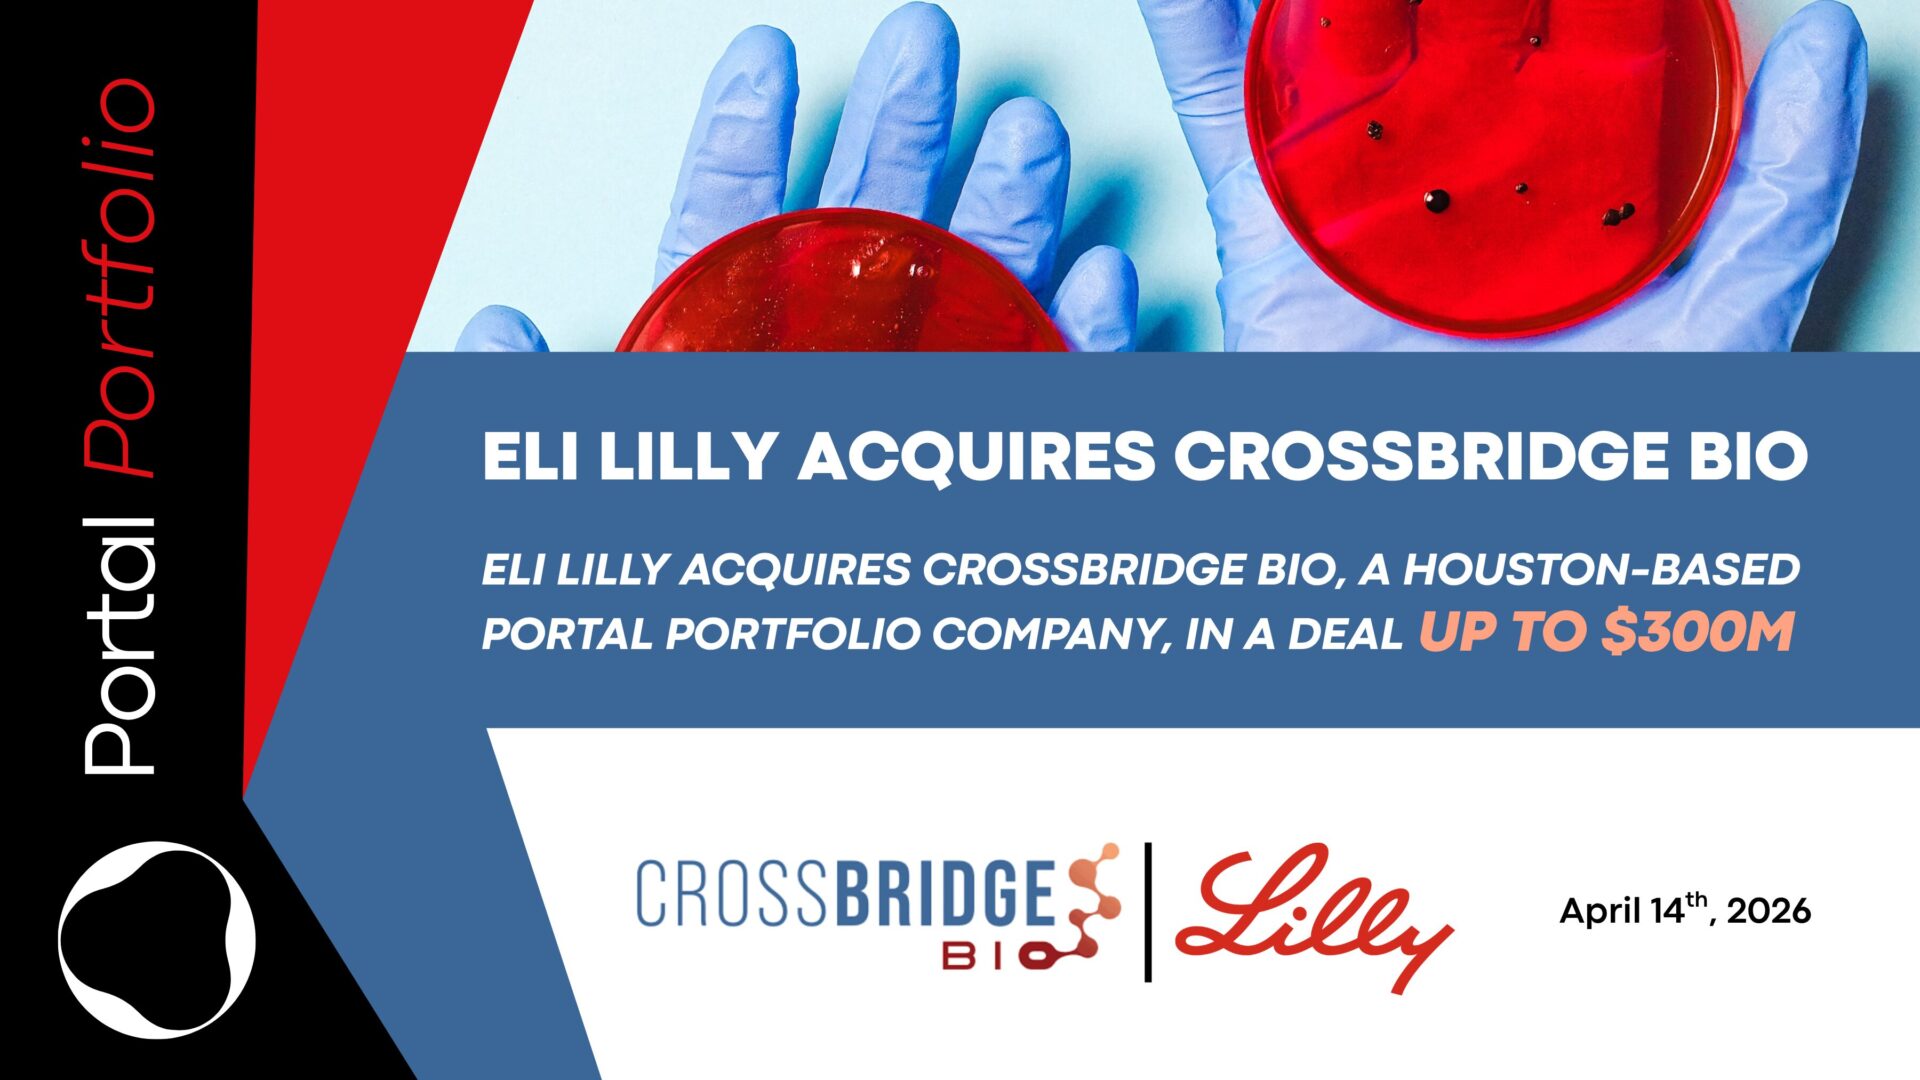

Portal Innovations is a venture development platform that helps exceptional science-driven innovators build their companies where they live. We surround these entrepreneurs with the resources and community they need: Seed capital, fully equipped lab space, and expertise and introductions to other investors and partners.

Founding sponsor
We are honored to have Walder Ventures as the founding sponsor of Portal Innovations. Our organizations share a bold vision to accelerate ambitious thinking in biomedical innovation and create a thriving ecosystem to support life science entrepreneurs. Read more.
Our partners